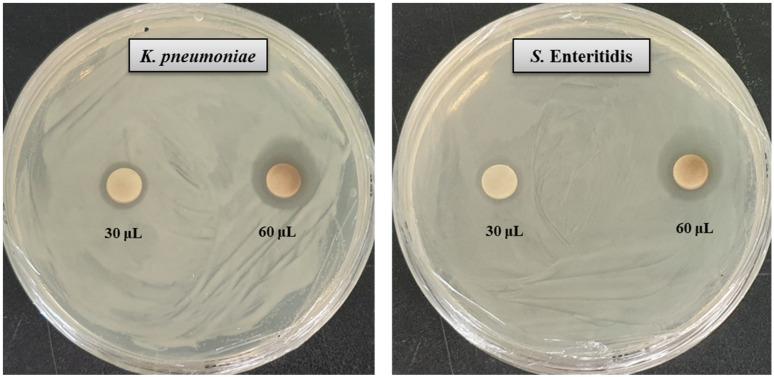
https://cdn.ncbi.nlm.nih.gov/pmc/blobs/3488/8512087/4577f462c82a/molecules-26-05996-g005.jpg

新型银纳米粒子的生物合成、表征及其对耐药性病原体和肠炎沙门氏菌的抗菌应用。
Biosynthesis, Characterization and Antibacterial Application of Novel Silver Nanoparticles against Drug Resistant Pathogenic and Enteritidis.
机构信息
Department of Food and Nutrition, College of Biotechnology and Natural Resource, Chung-Ang University, Anseong 17546, Korea.
Department of Food Science and Biotechnology, Gachon University, Seongnam 461-701, Korea.
出版信息
Molecules. 2021 Oct 2;26(19):5996. doi: 10.3390/molecules26195996.
The present study highlights the biosynthesis of silver nanoparticles (AgNPs) using culture supernatant of sp. MAHUQ-52 as well as the antimicrobial application of synthesized AgNPs against multi-drug resistant pathogenic and Enteritidis. Well-defined AgNPs formation occurred from the reaction mixture of cell-free supernatant and silver nitrate (AgNO) solution within 48 h of incubation. UV-visible spectroscopy analysis showed a strong peak at 435 nm, which corresponds to the surface plasmon resonance of AgNPs. The synthesized AgNPs were characterized by FE-TEM, EDX, XRD, DLS and FT-IR. From FE-TEM analysis, it was found that most of the particles were spherical shape, and the size of synthesized nanoparticles (NPs) was 15-55 nm. EDX spectrum revealed a strong silver signal at 3 keV. XRD analysis determined the crystalline, pure, face-centered cubic AgNPs. FT-IR analysis identified various functional molecules that may be involved with the synthesis and stabilization of AgNPs. The antimicrobial activity of sp. MAHUQ-52 mediated synthesized AgNPs was determined using the disk diffusion method against and Enteritidis. Biosynthesized AgNPs showed strong antimicrobial activity against both and Enteritidis. The MICs of synthesized AgNPs against and Enteritidis were 12.5 and 25.0 μg/mL, respectively. The MBC of biosynthesized AgNPs against both pathogens was 50.0 μg/mL. From FE-SEM analysis, it was found that the AgNPs-treated cells showed morphological changes with irregular and damaged cell walls that culminated in cell death.
本研究利用 sp. MAHUQ-52 的培养上清液合成了银纳米粒子(AgNPs),并研究了合成的 AgNPs 对多药耐药的 和 Enteritidis 病原菌的抗菌应用。在孵育 48 小时内,无细胞上清液和硝酸银(AgNO)溶液的反应混合物中发生了明确的 AgNPs 形成。紫外-可见光谱分析显示在 435nm 处有一个强峰,对应于 AgNPs 的表面等离子体共振。合成的 AgNPs 通过 FE-TEM、EDX、XRD、DLS 和 FT-IR 进行了表征。从 FE-TEM 分析中发现,大多数颗粒为球形,合成纳米颗粒(NPs)的大小为 15-55nm。EDX 光谱在 3keV 处显示出强烈的银信号。XRD 分析确定了结晶、纯、面心立方 AgNPs。FT-IR 分析确定了可能参与 AgNPs 合成和稳定的各种功能分子。采用圆盘扩散法测定 sp. MAHUQ-52 介导合成的 AgNPs 对 和 Enteritidis 的抗菌活性。生物合成的 AgNPs 对 和 Enteritidis 均表现出较强的抗菌活性。合成的 AgNPs 对 和 Enteritidis 的 MIC 分别为 12.5 和 25.0μg/mL。生物合成的 AgNPs 对两种病原体的 MBC 均为 50.0μg/mL。从 FE-SEM 分析中发现,AgNPs 处理的细胞表现出形态变化,细胞壁不规则且受损,最终导致细胞死亡。